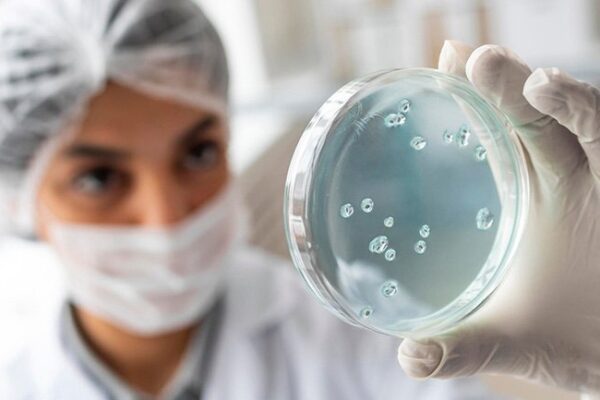

Сърцето бие бързо. Дишането се учестява. Светът се завърта, а в съзнанието изниква една-единствена мисъл: „Умирам ли?“


Сърцето бие бързо. Дишането се учестява. Светът се завърта, а в съзнанието изниква една-единствена мисъл: „Умирам ли?“

Ставите и всички части на опорно – двигателната система са системни жертви на обездвижване, залежаване и заседнал начин на живот по каквато и да е причина. Често тази част от нашето тяло бива пренебрегната, без да се взимат превантивни мерки за нейното добро здраве.

Витамините и минералите са важни вещества, необходими за нормалното функциониране на тялото и на ума. Те са есенциални, което означава, че организмът не може да си ги набави естествено, а трябва чрез определени храни и хранителни добавки.

Лековете за успокояването на нервната система са много, но не всеки от тях е толкова свеж и зареждащ с приятен аромат и вкус. Днес ще си поговорим за едно растение, което вирее във всяка бабина градина. То я краси със своя успокояващо зелен нюанс и свеж мирис на лимон.

Традиционната медицина на немалко страни е пълна с рецепти за лечебни чайове, приготвени от комбинацията на различни билки и естествени екстракти.

Пиенето на чай е не просто аспект на социализация и ритуал за релаксация. То притежава редица здравословни ползи по отношение на емоционалното и физическото състояние.

Все по-често се случва всеки втори човек да води заседнал начин на живот и това до голяма степен зависи от естеството му на работа или временно залежаване поради проблеми.
Представете си сценарий, в който собственото ви тяло не ви разпознава като свой приятел, а като враг и ви атакува За съжаление, това не сюжет на научно-фантастичен филм, а реалност за милиони хора по света, страдащи от автоимунни заболявания.
Напишете това, което искате да потърсите и натиснете ENTER. Натиснете ESC за да прекъснете.